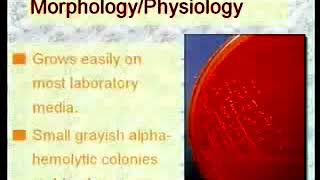

2.26. Bacillus, Listeria and Eryseplothrix II Medical Microbiology video
Online izle ve mp4 mp3 formatlarinda yukle
Videonun muddeti: 5:26
2.26. Bacillus, Listeria and Eryseplothrix II Medical Microbiology videosu mp4 ve mp3 yuklemek ucun hazirdir
Diqqet! Siz Mp4 yukle ve ya Mp3 yukle duymesine basdiqdan sonra eger sistem sizi reklam sehifesine atarsa o zaman derhal geri qayidib emeliyyati tekrar edin ve faylin yuklemek ucun hazir olmasini gozleyin
Videodan Mp4 Yukle
Videodan Mp3 Yukle-1
Videodan Mp3 Yukle-2
Oxshar Axtarishlar
2.26. Bacillus, Listeria and Eryseplothrix-II - Medical Microbiology
2.25. Bacillus, Listeria and Eryseplothrix-I - Medical Microbiology
listeria microbiology lecture ||Listeria ivanovii ||Easy Microbiology
listeria microbiology lecture ||listeria seeligeri ||Easy Microbiology
Listeria microbiology: Morphology, Pathogenesis, Diagnosis, Treatment
Listeria monocytogenes - Gram-positive bacteria - Microbiology review 🧫 #biology #science #medicine
Gram Positive Bacteria: Listeria monocytogenes
Introduction to Bacillaceae (Bacillus anthracis and Bacillus cereus) | Microbiology 🧫
Bacteria 2B: Clostridium, Corynebacterium, Listeria, Nocardia, Actinomyces, Bacillus (Presentation)
Video Mp4 Mp3Azwap.Biz
Azwap.Biz 2021-2023